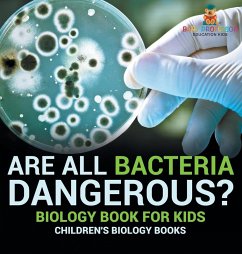

Bad Bug Busters
Vaccines vs. Germs
Versandkostenfrei!
Versandfertig in 1-2 Wochen
21,99 €
inkl. MwSt.
Weitere Ausgaben:

PAYBACK Punkte
11 °P sammeln!
Bad Bug Busters brings children on an entertaining and educational journey into the fascinating world of the immune system, making science exciting and accessible for young readers. Join Amelia as she discovers how the harmless 'training bugs' in vaccines transform immune cells into superheroes-always on the lookout for danger. If they find a bad bug, they fly into action, blocking, gobbling up, and exploding the bugs before they make you sick! Written for children aged 6-10 years, Bad Bug Busters combines scientific accuracy with bright and fun illustrations. The glossary in the back provides...
Bad Bug Busters brings children on an entertaining and educational journey into the fascinating world of the immune system, making science exciting and accessible for young readers. Join Amelia as she discovers how the harmless 'training bugs' in vaccines transform immune cells into superheroes-always on the lookout for danger. If they find a bad bug, they fly into action, blocking, gobbling up, and exploding the bugs before they make you sick! Written for children aged 6-10 years, Bad Bug Busters combines scientific accuracy with bright and fun illustrations. The glossary in the back provides scientific explanations of the bolded words throughout the book, offering an additional layer of learning as children grow. The author, an immunologist and mother of two, aims to educate and motivate children to overcome their fear of shots and to help parents, caregivers, teachers, and healthcare providers navigate the complex conversations around how vaccines work.